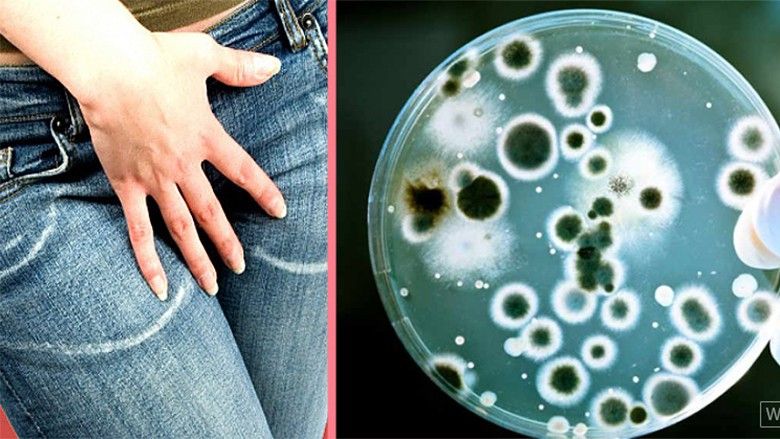

Kura natyrale për infeksionin mykotik
Infeksioni mykotik është një nga infeksionet më të përhapura tek femrat. Çdo femër, të paktën një herë në jetë, por ka edhe raste të tjera të cilave u përsëritët herë pas here, ndërsa mund te shfaqet edhe tek vajzat e vogla.
Infeksioni mykotik vaginal njihet ndryshe edhe si Candida, transmeton Telegrafi.
Kjo është një kërpudhë e zakonshme e pranishme në gojë, vagjinë, pore, lëkurë dhe traktin tretës. Kur është në sasi të vogla ky bakter nuk shkakton asnjë problem, por në rastet e një ulje të imunitetit për shkak të një sëmundje, diabetit, mbipeshës, shtatzënisë dhe përdorimit të antibiotikëve, ky infeksion mund të rëndohet.
Është normale që në trup të ketë kërpudha dhe tharm. E mbajnë nën kontroll florën e rregullt të përbërë nga bakteret vagjinale. Mirëpo, nganjëherë ajo baraspeshë çrregullohet dhe tharmi shumëfishohet shpejt dhe e shkakton infeksionin.
Ekzistojnë disa situata në të cilat tharmi mund të shumëzohet. Për shembull ilaçi antibiotik mund ta mbysë bakterin që e mban në rregull nivelin e tharmit. Kushtet në të cilat shkaktohen ndryshimet hormonale, siç janë: menopauza, shtatzënia, marrja e tabletave kontraceptive, diabeti gjithashtu, mund të shkaktojnë rritje të nivelit të tharmit.
Sekrecionet nga vagjina që janë te bardhë dhe duket si brumë ose si djathë.
Simptomat e tjera: kruarja, skuqja në pjesën e jashtme të vagjinës, djegia gjatë urinimit.
Disa gra të infektuara me candida mund të mos kenë kurrfarë simptomash. Tek mashkulli tharmi mund të shkaktojë ënjtje dhe skuqje në penis.
Si mjekohet? Aplikohet trajtimi me ilaçe. Infeksioni mund të mjekohet për disa ditë gjatë javës.
Si të kujdesemi për vetveten?
- Hiqni dorë nga marrëdhëniet seksuale derisa të mjekohet infeksioni.
- Ndiqni udhëzimet e mjekut për shfrytëzimin e ilaçeve.
- Hiqni dorë nga ushqimi me shumë sheqer.
- Mbani veshje të pambukta dhe ndërroni ato sa më shpesh.
- Hiqni dorë nga përdorimi i produkteve higjienike, siç janë shamponat, sprejet etj. në regjionin vagjinal. Përjashtohen rastet nëse këtë ua ka rekomanduar mjeku.
- Mbajeni të thatë zonën gjenitale.
- Dobësohuni, nëse jeni tepër mbipeshë.
- Nëse jeni me diabet, kushtoni kujdes nivelit të
sheqerit në gjak.
- Përpiquni që të konsumoni kos. Disa gra kanë dëshmuar se kosi ndihmon për ta penguar shtimin e tharmit.
- Vizitoni mjekun tuaj, nëse përsëritet infeksioni i tharmit në afatin prej dy muajve ose nëse infeksioni vazhdon të jetë edhe më tutje, me gjithë mjekimin.
Kosi është një nga produktet më të mira që bllokon shtimin e infeksionin mykotik. Thjesht ngrënia e kosit të ndihmon në parandalim, por edhe nëse lyeni një tampon me kos dhe e fusni brenda në vagjinë dy herë në ditë është një mënyrë për ta kuruar.
Soda e bukës është shumë e mirë për shpëlarje nga jashtë. Mbi të gjitha për vajzat e reja, mbushni një legen me ujë të ngrohtë dhe tretni në të pak sodë buke. Uleni brenda në legen për
disa minuta.
Edhe hudhra ndihmon në këtë rast.
Gjithashtu, vaji i holluar i pemës së çajit të gjelbër mund të përdoret për trajtimin e mykut vaginal.
Por në rastet kur nuk vërehet përmirësim, duhet marrë mjekimi i duhur të cilin do t'jua japi gjinekologu juaj. /Telegrafi/